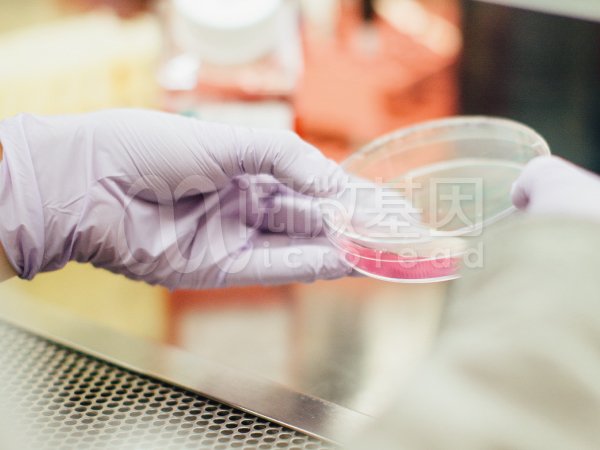

据《中国出生缺陷防治报告(2012)》指出我国是出生缺陷高发国家,根据世界卫生组织估计,我国出生缺陷发生率与世界中等收入国家的平均水平接近,约为5.6%,每年新增出生缺陷数约90万例,目前累计有3000万个家庭曾生育过出生缺陷患儿。随着我国社会经济的快速发展和医疗服务水平的提高,婴儿死亡率和5岁以下儿童死亡率持续下降,危害儿童健康的传染性疾病逐步得到有效控制,出生缺陷问题开始凸显,逐渐成为影响儿童健康和出生人口素质的重大公共卫生问题。
出生缺陷三级预防
出生缺陷是婴儿死亡的主要原因、是儿童残疾的重要原因、疾病负担巨大。我国政府高度重视出生缺陷防治工作,坚持出生缺陷综合防治策略,大力推广三级预防措施,降低出生缺陷。

阅微基因生殖遗传产品线全面覆盖出生缺陷三级预防的各个阶段,通过孕前、产前筛查,提前进行遗传咨询和产前诊断,有效避免患儿的出生,新生儿筛查有助于疾病的提前干预和治疗,全面致力于出生缺陷的预防。
阅微基因基于毛细管电泳平台(一代测序金标准平台),开发了一系列血液、血卡免DNA 提取产品,不仅包括脆性X综合征、脊髓性肌萎缩症、遗传性耳聋等遗传病基因检测产品,同时还包括染色体非整倍体、母体细胞污染检测等助力于产前诊断的产品,多款试剂盒完美搭配智阅基因分析仪及自主研发数据分析系统,全方位灵活解决临床各方面需求,为临床提供整体解决方案。
服务科室及机构
妇产科、产前诊断中心、检验科、中心实验室、精准医学中心、第三方医学检验所
适用人群
■ 孕产妇产前筛查:防止患儿出生
■ 新生儿筛查:提前预防、干预疾病
■ 适龄人群婚前指导:指导生育、避免生出患儿
■ 相关疾病患者:病因诊断
■ 关注自身健康的正常人:确定是否是携带者
■ 有相关疾病家族史的人群:确定是否是携带者







